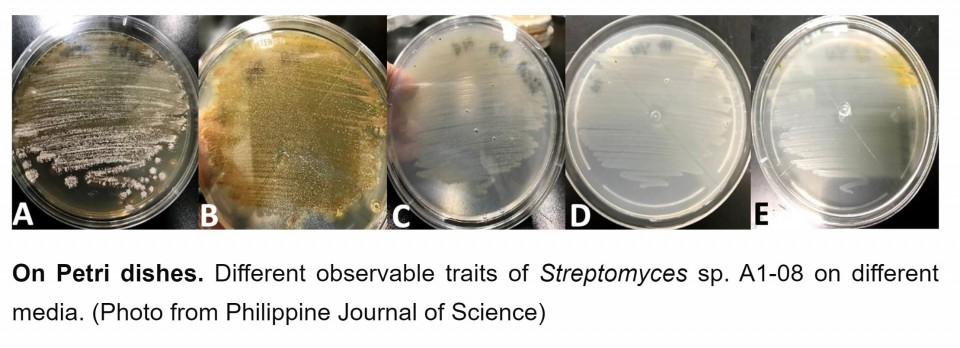

Soil from from Mt. Mayon volcano has been found to host bacteria that has potential antibiotic and anticancer properties, according to researchers from the University of the Philippines Los Baños (UPLB).
The researchers identified a specific bacterial species from the soils of Mt. Mayon that has shown potential antibiotic and anti-colorectal cancer activities.
“This specific bacterial isolate identified as Streptomyces sp. A1-08 has shown antibiotic activity against numerous potentially pathogenic microorganisms and anti-colorectal cancer potential. It is one of the 30 bacteria that were isolated from soil samples of Mt. Mayon in Malilipot, Albay,” the Department of Science and Technology (DOST)said in a release.
“From now on, Mt. Mayon will be known not only for its perfect cone shape and eruptive past but for its soils that host bacteria that has potential antibiotic and anticancer properties,” the DOST said.
“We have high hopes of getting new and novel species because this is a less explored environment, a volcano”, said Kristel Mae P. Oliveros, the project leader and an assistant professor in UPLB Microbiology Division. “We were totally surprised and excited,” she added while describing how they felt upon finding out the results of their experiments.
Once the researchers have confirmed that Streptomyces sp. A1-08 is a new species, they will name it “Streptomyces mayonensis A1-08” in honor of our country. This was explained by Asst. Prof. Oliveros’ coworker Albert Remus R. Rosana who is currently a PhD student at the University of Alberta, Canada.
The researchers have initially isolated 30 bacterial species from Mt. Mayon’s volcanic soils. Thirteen of them have shown varying antibiotic activities in different test organisms that were known as pathogenic to humans or plants. The test organisms are Salmonella enterica serovar Typhimurium, Klebsiella pneumoniae, Staphylococcus aureus and its methicillin-resistant variant, Candida albicans, Aspergillus niger, and an unspecified Fusarium species.
“One of the objectives of the study is to screen actinomycete isolates for antimicrobial activity. Therefore, we ensured that our selected test organisms would represent some of the major groups of microorganisms, including bacteria, yeasts, and molds to capture a broader antimicrobial spectrum result,” Asst. Prof. Oliveros mentioned.
“The choice of test organisms was also associated with World Health Organization’s (WHO) list of human pathogens that post eminent danger to human health by 2050, mainly due to antibiotic resistance,” Rosana added.
The research team assumed that since those 30 isolates thrive in a unique environment such as Mt. Mayon’s volcanic soils, they most likely produce unique chemical compounds that may have medical, pharmaceutical, and even cosmeceutical uses. Moreover, Streptomyces species in general are known to produce medically and pharmaceutically important products.

But Streptomyces sp. A1-08 stood out because it has shown antagonistic effects on all test microorganisms and the methicillin-resistant Staphylococcus aureus or simply MRSA. Abundant in hospitals, MRSA is strongly resistant against antibiotics which makes treatment of infections more difficult. In fact, the WHO has declared antimicrobial resistance as one of the top 10 global threats to public health.
-Anticancer, genomic tests-
Because Streptomyces sp. A1-08 seems to fight off MRSA, this prompted Asst. Prof. Oliveros and team to study Streptomyces sp. A1-08 further using the anti-colorectal cancer test and genomic analysis.
Their anti-colorectal cancer test indicates that crude extracts from Streptomyces sp. A1-08 suggested low potency when compared to a doxorubicin, a chemotherapy drug.
“It is good to remember that the positive control doxorubicin is a pure, proven and tested commercially available chemotherapy drug. In contrast, the ethyl acetate extract of [Streptomyces sp.] A1-08 which we have used in the study, [is] a crude extract, and therefore still a complex mixture and may contain multitude of raw compounds at different concentrations,” Asst. Prof. Oliveros explained.
Those raw compounds can be purified further to develop an exact anticancer drug.
To identify the specific genes of Streptomyces sp. A1-08 responsible for producing antibiotic and anticancer compounds, the researchers conducted genomics analysis – or the study of the organism’s complete set of DNAs. It also helped them zero in on the specific identity of Streptomyces sp. A1-08.
disco
Rosana likened genomics to a blueprint of a house or different Lego pieces that a person can assemble to build their favorite character. “In our genomics work, we use computer software to build the correct sequence of the Lego pieces and predict target outcomes, which in our research are the different antibiotics and potential anti-cancer molecules,” he added.
-“Jackpot” discovery-
Discovery is not the end
Asst. Prof. Oliveros defined their findings as a “jackpot” but pointed out that their discovery must lead to more research.
“Way forward, further studies should be made for us to establish that this novel species can likewise produce novel bioactive compounds,” she mentioned.
“Future rigorous research in drug chemistry combined with metabolomics are vital to claim that the secondary metabolites produced by our isolate is totally new and hopefully effective as a chemotherapy drug,” said Asst. Prof. Oliveros.
Metabolomics is the study of metabolites involved in chemical processes happening in an organism.
“This is also our dream, to put this project forward in the large-scale cosmeceutical and pharmaceutical pipeline!” the UPLB researcher added.
She finds it honorable to pioneer extending their discovery to industrial applications, and “to showcase the known and great potential of the Philippines as a promising land that harbor natural products for drug discovery”.
This paper was recently accepted in the Philippine Journal of Science (PJS), a peer-reviewed publication of the Department of Science and Technology. Although the paper is lined up on the PJS’ December 2021 issue, its full copy will be uploaded immediately on the journal’s website (philjournalsci.dost.gov.ph) as soon as its ready for public reading.
Joining Rosana and Oliveros in their groundbreaking work are Andrew D. Montecillo, Dr. Rina B. Opulencia, Arian J. Jacildo, Dr. Asuncion K. Raymundo, and the late Dr. Teofila O. Zulaybar, who are all from UPLB.
This study was funded by the UPLB Basic Research Grant and scholarship grants given to Albert Rosana.
(From DOST, David Matthew C. Gopilan, DOST-STII)





